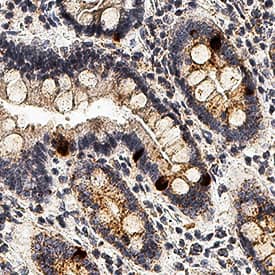
IL-10 antibody in Human Duodenum by Immunohistochemistry (IHC-P).

Human IL-10 Antibody
R&D Systems, part of Bio-Techne | Catalog # MAB91842


Key Product Details
Species Reactivity
Validated:
Cited:
Applications
Validated:
Cited:
Label
Antibody Source
Product Specifications
Immunogen
Met1-Asn178
Accession # P22301
Specificity
Clonality
Host
Isotype
Scientific Data Images for Human IL-10 Antibody
Detection of Human IL‑10 by Western Blot.
Western blot shows lysates of HEK293 human embryonic kidney cell line either mock transfected or transfected with human IL-10. PVDF membrane was probed with 1 µg/mL of Rabbit Anti-Human IL-10 Monoclonal Antibody (Catalog # MAB91842) followed by HRP-conjugated Anti-Rabbit IgG Secondary Antibody (Catalog # HAF008). A specific band was detected for IL-10 at approximately 17 kDa (as indicated). This experiment was conducted under reducing conditions and using Immunoblot Buffer Group 1.IL-10 in Human Duodenum.
IL-10 was detected in immersion fixed paraffin-embedded sections of human duodenum using Rabbit Anti-Human IL-10 Monoclonal Antibody (Catalog # MAB91842) at 3 µg/mL for 1 hour at room temperature followed by incubation with the Anti-Rabbit IgG VisUCyte™ HRP Polymer Antibody (Catalog # VC003). Before incubation with the primary antibody, tissue was subjected to heat-induced epitope retrieval using Antigen Retrieval Reagent-Basic (Catalog # CTS013). Tissue was stained using DAB (brown) and counterstained with hematoxylin (blue). Specific staining was localized to cytoplasm in enteroendocrine cells of duodenum. View our protocol for IHC Staining with VisUCyte HRP Polymer Detection Reagents.Applications for Human IL-10 Antibody
Immunohistochemistry
Sample: Immersion fixed paraffin-embedded sections of human duodenum
Western Blot
Sample: HEK293 human embryonic kidney cell line transfected with human IL-10
Formulation, Preparation, and Storage
Purification
Reconstitution
Formulation
Shipping
Stability & Storage
- 12 months from date of receipt, -20 to -70 °C as supplied.
- 1 month, 2 to 8 °C under sterile conditions after reconstitution.
- 6 months, -20 to -70 °C under sterile conditions after reconstitution.
Background: IL-10
Interleukin 10, also known as cytokine synthesis inhibitory factor (CSIF), is the charter member of the IL-10 family of alpha-helical cytokines that also includes IL-19,
IL‑20, IL-22, IL-24, and IL-26/AK155 (1, 2). IL-10 is secreted by many activated hematopoietic cell types as well as hepatic stellate cells, keratinocytes, and placental cytotrophoblasts (2‑5). Mature human IL-10 shares 72%‑86% amino acid sequence identity with bovine, canine, equine, feline, mouse, ovine, porcine, and rat IL-10. Whereas human IL-10 is active on mouse cells, mouse IL-10 does not act on human cells (6, 7). IL-10 is a 178 amino acid molecule that contains two intrachain disulfide bridges and is expressed as a 36 kDa noncovalently associated homodimer (6, 8, 9). The IL-10 dimer binds to two IL-10 R alpha/IL-10 R1 chains, resulting in recruitment of two IL-10 R beta/IL-10 R2 chains and activation of a signaling cascade involving JAK1, TYK2, and STAT3 (10). IL-10 R beta does not bind IL-10 by itself but is required for signal transduction (1). IL-10 R beta also associates with IL‑20 R alpha, IL-22 R alpha, or IL-28 R alpha to form the receptor complexes for IL-22, IL-26, IL-28, and IL‑29
(11‑13). IL-10 is a critical molecule in the control of viral infections and allergic and autoimmune inflammation (14‑16). It promotes phagocytic uptake and Th2 responses but suppresses antigen presentation and Th1 proinflammatory responses (2).
References
- Pestka, S. et al. (2004) Annu. Rev. Immunol. 22:929.
- O’Garra, A. and P. Vieira (2007) Nat. Rev. Immunol. 7:425.
- Mathurin, P. et al. (2002) Am. J. Physiol. Gastrointest. Liver Physiol. 282:G981.
- Grewe, M. et al. (1995) J. Invest. Dermatol. 104:3.
- Szony, B.J. et al. (1999) Mol. Hum. Reprod. 5:1059.
- Vieira, P. et al. (1991) Proc. Natl. Acad. Sci. 88:1172.
- Hsu, D.-H. et al. (1990) Science 250:830.
- Windsor, W.T. et al. (1993) Biochemistry 32:8807.
- Syto, R. et al. (1998) Biochemistry 37:16943.
- Kotenko, S.V. et al. (1997) EMBO J. 16:5894.
- Kotenko, S.V. et al. (2000) J. Biol. Chem. 276:2725.
- Hor, S. et al. (2004) J. Biol. Chem. 279:33343.
- Sheppard, P. et al. (2003) Nat. Immunol. 4:63.
- Fitzgerald, D.C. et al. (2007) Nat. Immunol. 8:1372.
- Wu, K. et al. (2007) Cell. Mol. Immunol. 4:269.
- Blackburn, S.D. and E.J. Wherry (2007) Trends Microbiol. 15:143.
Long Name
Alternate Names
Entrez Gene IDs
Gene Symbol
UniProt
Additional IL-10 Products
Product Documents for Human IL-10 Antibody
Product Specific Notices for Human IL-10 Antibody
For research use only